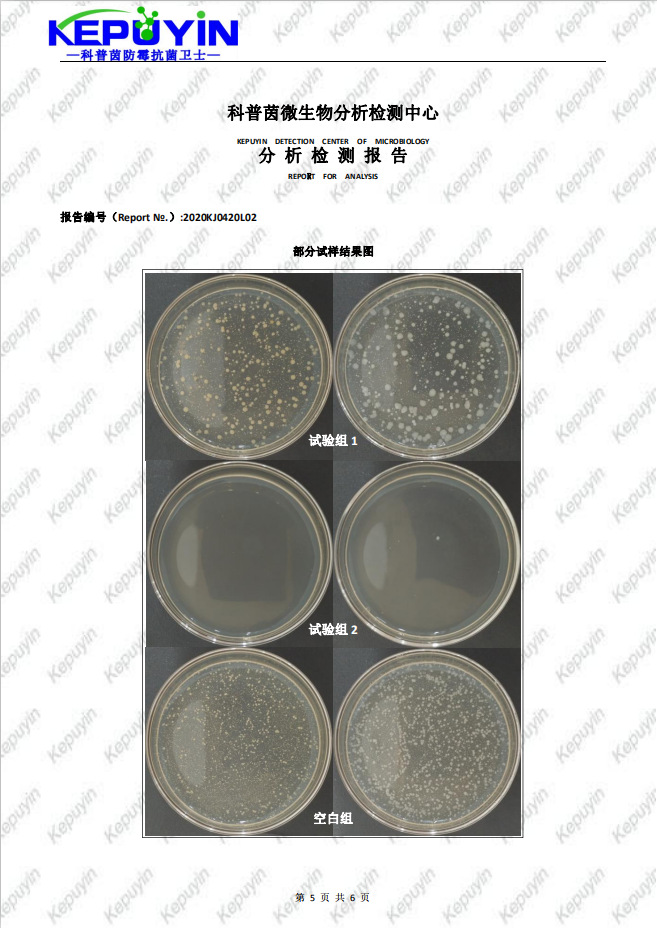
undefined
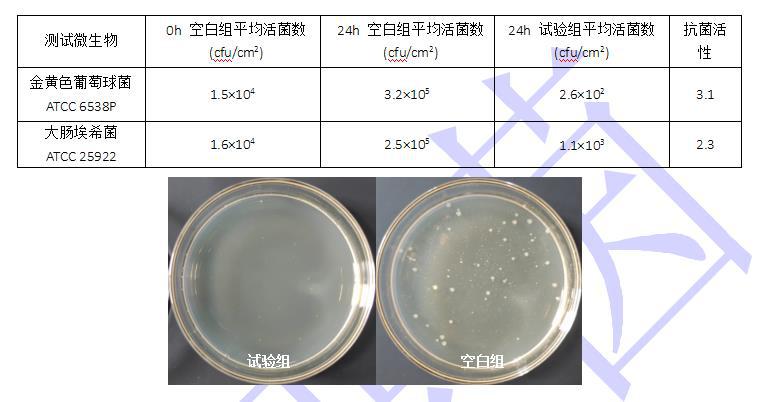
undefined

亚克力透明抗菌剂 高透塑料耐高温防霉抗菌剂 应用
- 供应商
- 佛山科普茵生物科技有限公司
- 认证
- 品牌
- 科普茵
- 型号
- KEPUYIN-J170
- 产地
- 广东
- 联系电话
- 0757-88788686
- 手机号
- 18620907734
- 经理
- 陈师
- 所在地
- 佛山市南海区大沥镇盐步横江横沙路88号厂房的2楼(住所申报)
- 更新时间
- 2021-10-22 11:03


透明耐高温抗菌剂KEPUYIN-J170是由多种有机抗菌剂经耐高温处理后复配制得;该产品解决了无机抗菌剂和高熔点抗菌剂在塑料上不相容、熔点高、雾度高影响材料透明度等问题。对大肠杆菌、金黄色葡萄球菌、白色念珠菌等各类致病菌都有优异的抗菌作用,广谱杀菌,使用浓度无毒无刺激。目前已广泛应用于各种塑料领域。


※抗菌性能优异、杀菌广谱、对多种细菌、霉菌有明显抗菌效果;
※理化性质稳定、热稳定性大于300℃,对UV及雨水冲刷耐受性好,户外使用不会失效;
※环保配方,不含有害重金属,符合Rosh,Reach等法规;
※熔点低、不变色,可用于透明薄膜、超细纤维等特殊场合;
※透明,可与增塑剂、有机载体及稀释剂混溶,使用方便。其不会与助剂发生反应,不影响制品性能。


适用于涂料、各种塑料制品的抗菌剂,尤其适用于以PC/PP/PE/ABS/HIPS/PVC/PBT等为基料的注塑和挤出制品如可以制成抗菌冰箱、抗菌洗衣机、抗菌电话、抗菌板、抗菌玩具、抗菌键盘、抗菌纱线、抗菌刷、抗菌马桶盖板、抗菌医疗器械等等。

可添加到各种合成树脂的原材料(如PP、PPR、PS、PE、TPE、PC、PET、PBT、AS、PU、ABS、PA等)中。在加入到合成树脂的原材料中时,可根据具体生产情况直接使用选择粉末制剂或先抽粒成5~10%的抗菌树脂母粒。
在加入到涂料、粘合剂中时,只需将粉末制剂直接加入即可。
一般0.1%~0.3%即可达到很好的抗菌效果。

透明耐高温抗菌剂KEPUYIN-J170的作用机理是先吸附于细菌细胞壁,再穿透细胞壁,与细胞质的脂质、蛋白质反应,产生不可逆变性,杀死细菌。是一种非离子型化合物,对革兰氏阳性菌、革兰氏阴性菌、霉菌、酵母菌、病毒等具有广泛、高效的杀灭和抑制作用。
在ABS本料样品添加0.2%的透明耐高温抗菌剂KEPUYIN-J170进行注塑成型,测试标准ISO 22196塑料制品表面抗菌性能评价方法测试结果见下表:
测试标准
* QB/T2591-2003抗菌塑料-抗菌性能试验方法和抗菌效果,附录A:抗菌塑料-抗细菌性能试验方法
* JISZ 2801-2000抗菌产品抗菌活性和效果的试验
* AATCC 100-2004纺织材料抗菌整理剂的评定
* GB/T 20944 纺织品抗菌性能评价
* JIS L 1902-2008纺织品抗菌性能的检测与评价

注意事项
使用操作时必须戴手套、防护口罩和护目镜,避免接触皮肤。一旦大量吸入和眼睛接触立即用大量清水及肥皂清洗并及时就医。
包装储存
包装及规格:化工纸装,25kg/桶。密封储存,避免吸潮后不易分散。



